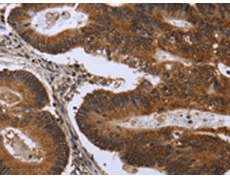
一抗

|
Background: |
This gene encodes a largely hydrophilic centrosomal protein that is required for anchoring microtubules to subcellular structures. A t(6;8)(q27;p11) chromosomal translocation, fusing this gene and the fibroblast growth factor receptor 1 (FGFR1) gene, has been found in cases of myeloproliferative disorder. The resulting chimeric protein contains the N-terminal leucine-rich region of this encoded protein fused to the catalytic domain of FGFR1. Alterations in this gene may also be associated with Crohn's disease, Graves' disease, and vitiligo. Alternatively spliced transcript variants that encode different proteins have been identified. |
|
Applications: |
ELISA, IHC |
|
Name of antibody: |
FGFR1OP |
|
Immunogen: |
Fusion protein of human FGFR1OP |
|
Full name: |
FGFR1 oncogene partner |
|
Synonyms: |
FOP |
|
SwissProt: |
O95684 |
|
ELISA Recommended dilution: |
2000-10000 |
|
IHC positive control: |
Human colon cancer and human cervical cancer |
|
IHC Recommend dilution: |
100-300 |

 購(gòu)物車
購(gòu)物車 幫助
幫助
 021-54845833/15800441009
021-54845833/15800441009